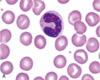
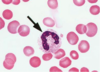
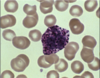
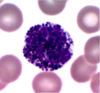
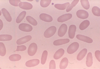
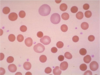
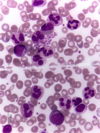
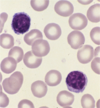
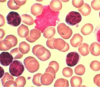
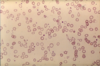
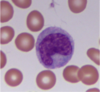
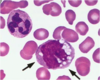
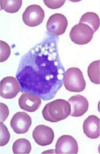
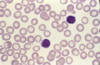
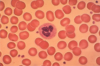
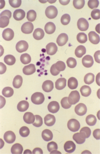
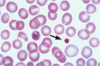
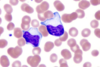
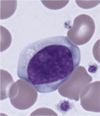
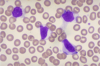
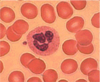
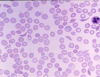
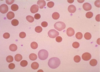

Lecture 23: Heart Vessels Blood/Microstructure, Histology Flashcards
(36 cards)
1
Q
A
band neutrophil
2
Q
A
band neutrophil
3
Q
A
basophil
4
Q
A
basophil
5
Q
A
elliptocytes
6
Q

A
erythroblasts - bone marrow
7
Q
A
erythrocytes - blood
8
Q

A
erythrocytes-blood
9
Q

A
leukocytosis (granulocytosis) - Chronic Myelogenous Leukemia
10
Q
A
Leukocytosis (Granulocytosis) – Chronic Myelogenous Leukemia
11
Q
A
lymphocyte
12
Q

A
lymphocyte
13
Q
A
lymphocyte
14
Q

A
lymphocyte
15
Q

A
megakaryocyte
16
Q

A
megakaryocyte
17
Q
A
mirocytes
18
Q

A
monocyte
19
Q
A
monocyte
20
Q
A
monocyte
21
Q
A
monocyte
22
Q
A
normal red blood cells
23
Q

A
normochromic, normocytic red blood cells
24
Q
A
peripheral blood smear
25
platelet clumping-in vitro artifact
26
platelets
27
reactive "atypical" lymphocyte
28
reactive "atypical" lymphocyte
29
reactive "atypical" lymphocyte
30

red blood cells
31
segmented neutrophil
32

segmented neutrophil
33
sickle cells
34
spherocytes
35

yellow marrow-white; red marrow-pink
36


